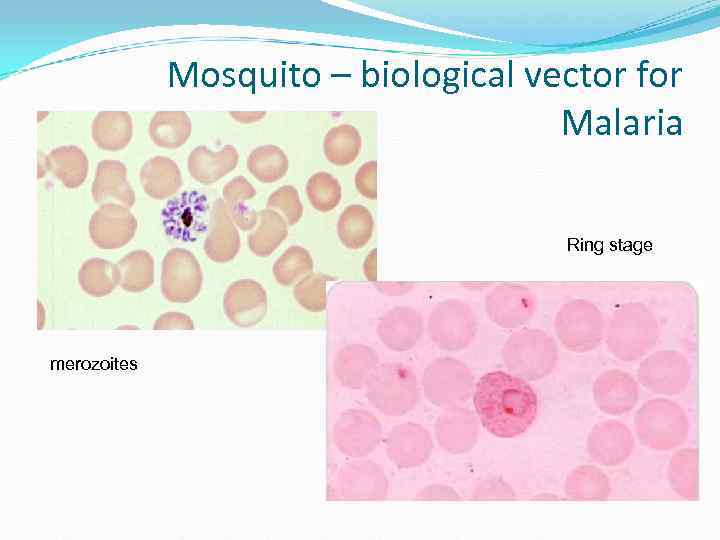
Mosquito – biological vector for Mosquito – biological vector for

Медицинская паразитология введение раздел

Паразитология 1. ВВЕДЕНИЕ.ppt
- Количество слайдов: 94
Медицинская паразитология введение
раздел медицины, изучающий паразитов человека и вызываемые ими заболевания и патологические состояния, способы профилактики заражения, способы лечения заражённого или заболевшего человека.
Делится на разделы: -мед. протозоология(представители типа простейшие); -мед. арахноэнтомологию (представители типа членистоногие- клещи, насекомые); - мед. гельминтология (гельминты, паразитирующие у человека из типа плоских и круглых червей)
1) изучение особенностей строения паразитов на всех стадиях развития; 2) изучение систематики обьектов паразитологии, принадлежность к той или иной паразитической группе; 3) изучение взаимоотношения паразит-хозяин; 4) изучение особенностей цикла развития паразитов и преносчиков, установление путей циркуляции паразитов в природе и способы попадания в организм человека; 5) разработка научных основ диагностики и лечения паразитарных заболеваний на основании знания вредоносного действия паразитов, а также методов профилактики и борьбы с паразитами и переносчиками; 6) создание системы, обеспецивающей профилактику и ликвидацию паразитарных заболеваний
.
1. Нейтрализм - тип биотической связи, при которой совместно обитающие на одной территории организмы не влияют друг на друга. При нейтрализме особи разных видов не связаны друг с другом непосредственно.
2. Симбиоз - сожительство (от. греч. сим - вместе, биос - жизнь) - форма взаимоотношения, из которых оба партнера или хотя бы один извлекают пользу.
Виды симбиоза: Мутуализм - форма симбиоза, при которой присутствие каждого из двух видов становится обязательным для обоих, каждый из сожителей получает относительно равную пользу, и партнеры (или один из них) не могут существовать друг без друга. пример мутуализма - отношения термитов и жгутиковых простейших, обитающих в их кишечнике.
Виды симбиоза: Протокооперация - форма симбиоза, при которой совместное существование выгодно для обоих видов, но не обязательно для них. В этих случаях отсутствует связь именно этой, конкретной пары партнеров. Например, взаимоотношение мелких рыбок семейства губановых и крупных хищных мурен.
Виды симбиоза: Комменсализм - форма симбиоза, при которой один из сожительствующих видов получает какую-либо пользу, не принося другому виду ни вреда, ни пользы.
Виды комменсализма "Квартиранство" - форма комменсализма, при которой один вид использует другой (его тело или его жилище) в качестве убежища или своего жилья. горчак откладывает икру в мантийную полость двухстворчатых моллюсков - беззубок.
Виды комменсализма "Сотрапезничество"- форма комменсализма, при которой несколько видов потребляют разные вещества или части одного и того же ресурса.
Виды комменсализма "Нахлебничество" - форма комменсализма, при которой один вид потребляет остатки пищи другого. Например, взаимоотношения рыбы-прилипалы, с акулами и китообразными.
3. Антибиоз - тип биотической связи, когда обе взаимодействующие популяции(или одна из них) испытывают отрицательное влияние друга.
Виды антибиоза Аменсализм - форма антибиоза, при которой один из совместно обитающих видов угнетает другой, не получая от этого ни вреда, ни пользы. Пример: светолюбивые травы, растущие под елью, страдают от сильного затемнения, в то время как сами на дерево никак не влияют.
Виды антибиоза Хищничество - тип антибиоза, при котором представители одного вида питаются представителями другого вида. Хищничество широко распространено в природе как среди животных, так и среди растений.
Виды антибиоза Кокуренция - тип биотических взаимоотношений, при котором организмы или виды соперничают друг с другом в потреблении одних и тех же обычно ограниченных ресурсов. Конкуренцию подразделяют на внутривидовую и межвидовую.
Внутривидовая кокуренция - соперничество за одни и те же ресурсы, происходящее между особями одного и того же вида. Это важный фактор саморегулирования популяции.
Межвидовая кокуренция 11 - соперничество за одни и те же ресурсы, происходящее между особями разных видов.
Виды антибиоза Паразитизм - форма антибиоза, когда представители одного вида используют питательные вещества или ткани особей другого вида, а также его самого в качестве временного или постоянного местообитания.
Паразитизм, как экологический феномен Паразитизм — это универсальное, широко распространенное в живой природе явление, состоящее в использовании одного организма другим в качестве источника питания. При этом паразит причиняет хозяину вред вплоть до гибели.
Пути возникновения паразитизма 1. Переход свободноживущих форм (хищников) к эктопаразитизму при увеличении времени возможного существования без пищи и времени контакта с жертвой.
Пути возникновения паразитизма 2. Переход от комменсализма (сотрапезничества, нахлебничества, ситуации, когда хозяин служит лишь средой обитания) к эндопаразитизму в случае использования комменсалами не только отходов, но части пищевого рациона хозяина и даже его тканей.
Пути возникновения паразитизма 3. Первичный эндопаразитизм в результате случайного, часто неоднократного заноса в пищеварительную систему хозяина яиц и цист паразитов.
Среда обитания паразитов Среда первого порядка – органы хозяина и другие населяющие его паразиты Среда второго поорядка – внешняя среда, окружающая хозяина, которая действует на паразитов опосредованно, через тело хозяина
Особенности среды обитания паразитов 1. Постоянный и благоприятный уровень температуры и влажности. 2. Обилие пищи. 3. Защита от неблагоприятных факторов. 4. Агрессивный химический состав среды обитания (пищеварительные соки).
Классификация паразитических форм животных Облигатные паразиты – паразитическиф образ жизни – обязательная форма существования. Факультативные паразиты – свободно-живущие организмы, которые при случайном попадании в подходящих хозяев могут вести паразитический образ жизни
В зависимости от времени, проводимом на хозяине постоянные, если никогда не встречаются в свободноживущем состоянии
В зависимости от времени, проводимом на хозяине временные, если связаны с хозяином только во время приема пищи
По месту обитания на хозяине Эктопаразиты живут на поверхности организма хозяина
По месту обитания на хозяине Внутрикожные паразиты, обитающие в толще кожных покровов хозяина Чесоточний зудень
По месту обитания на хозяине Круглые черви Полостные паразиты, обитающие в полостях различных органов хозяина, сообщающихся с внешней средой Ленточные черви
Простейшие – полостные паразиты
По месту обитания на хозяине Эндопаразиты обитающие во внутренних органах организма хозяина, клетках и плазме крови -паразиты жидкостей внутренней среды -внутривлеточные паразиты
Источники и способы проникновения паразитов в организм человека
1) алиментарный (пероральный): - геооральный (через руки, продукты питания или предметы обихода, а также через шерсть и перья домашних животных и птиц, загрязненные частицами почвы, содержащей инвазионные яйца гельминтов и цисты простейших) – при аскаридозе, энтеробиозе, лямблиозе, токсокарозе, эхинококкозе, цистицеркозе и др. - ксенотрофный (при потреблении в пищу недостаточно термически обработанного мяса, рыбы, содержащих инвазионные личинки паразитов) – при токсоплазмозе, трихинеллезе и тениозе и т. д.
СПОСОБ ЗАРАЖЕНИЯ ИСТОЧНИК ЗАРАЖЕНИЯ ПЕРОРАЛЬНЫЙ ПОЧВА (алиментарный) Яйца с личинками, которые находятся в почве
Ascaris lumbricoides
Личинка аскариды в ткани легкого
Локализация паразита
Мигрирующая личинка аскариды «larva migrants»
СПОСОБ ЗАРАЖЕНИЯ ИСТОЧНИК ЗАРАЖЕНИЯ ПЕРОРАЛЬНЫЙ ВОДА (алиментарный) Инфекционная стадия может быть проглочена с водой
Entamoeba histolytica Trophozoite Cyst stage
LUNG DIAPHRAGM SKIN LIVER Portal circulation PRIMARY INFECTION IN COLON General BRAIN Perianal skin circulation GENITALS KIDNEY SPLEEN
Fasciola hepatica
Способ заражения Источник заражения ПЕРОРАЛЬНЫЙ ВОДА С водой может быть проглочек промежуточный хозяин паразита (с личинкой)
Заражение риштой происходит при питье сырой нефильтрованной воды, содержащей циклопа – промежуточного хозяина ришты
Способ заражения Источник заражения ПИЩА ПЕРОРАЛЬНЫЙ Мясо, содержащее личиночные формы
Финны бычьего и свиного цепней (цистицерки)
Taenia solium Taenia saginata
Промежуточные хозяева Для Бычьего цепня. . … Для свиного цепня
Часто человек может быть промежуточным хозяином для свиного цепня Инвазионная стадия – яйцо с онкосферой В организме развивается цистицерк
Человек ВСЕГДА ОДНОВРЕМЕННО окончательный и промежуточный озяин для Инкапсулированная личинка в мышцах – трихинеллы (промежуточный хозяин)
Взрослая стадия в тонком кишечнике – (окончательный хозяин)
Источники и способы проникновения паразитов в организм человека 2) контактно-бытовой (пассивный) (через предметы домашнего обихода, от зараженных членов семьи, домашних кошек и собак); через пыль, игрушки, ковры, нательное и постельное белье и руки попадают в пищевой тракт.
Способ заражения Источник заражения Контактно-бытовой ЧЕЛОВЕК (при контактах) Паразитические инфекции могут передаваться непосредственно от человека к человеку при прямых контактах (поцелуях, половых контактах, рукопожатии)
чесотка
фтириоз
При поцелуях – ротовая амеба
При половых контактах - трихомоноз Trichomonas vaginalis
При контакте с предметами, игрушками, к которым прикасался больной Яйца острицы
Способ заражения Источник заражения Контактный ЖИВОТНЫЕ Паразитические инфекции могут передаваться человеку при контакте с домашними или дикими животными
Финны эхинококка Окончательный хозяин – собаки, волки, шакалы, лисы
Источники и способы проникновения паразитов в организм человека 3) перкутантный или активный (личинка проникает через кожу или слизистые оболочки во время контакта с зараженной почвой, при купании в открытых водоемах).
СПОСОБ ЗАРАЖЕНИЯ ИСТОЧНИК ЗАРАЖЕНИЯ ПРОНИКНОВЕНИЕ ПОЧВА СКВОЗЬ КОЖУ Личинка из почвы может активно пробуравливать кожные покровы
Ancylostoma duodenale (hookworm) Личинка анкилостомы
Ancylostoma duodenale (hookworm)
Способ заражения Источник заражения ПРОНИКНОВЕНИЕ ВОДА ЧЕРЕЗ КОЖУ Личинка в воде может активно вбуравливаться через кожу
Церкария шистосомы
Взрослые черви живут в венах брыжейки, кишечника и мочеполовой системы
Источники и способы проникновения паразитов в организм человека 4) трансмиссивный - инокулятивный (возбудитель проникает в кровь инокулятивный хозяина через ротовой аппарат переносчика – вектора) - контаминативный (возбудитель выделяется контаминативный переносчиком с фекалиями либо иным способом на кожу или слизистые оболочки и оттуда попадает в организм хозяина через рану от укуса, царапины, расчесы и т. п. )
Биологические векторы: Комары
Wuchirreria bancrofti
Filarial Loa loa warm Onchocerca volvulus
Mosquito – biological vector for Malaria Ring stage merozoites
Москиты – биологические векторы для Кала-Азар, лейшманиоза Инфекционные стадии - промастиготы
cutaneous leishmaniasis Кожный лейшманиоз
Висцеральный лейшманиоз (Kala- Azar)
Муха Це-Це – биологический вектор для Африканской сонной болезни
Африканская сонная болезнь Лихорадка, головная боль Увеличение печени и селезенки Умственная дегенерация Апатия Сонное, вялое состояние
Контаминативный – вши – переносчики возбудителей вшивого сыпного и возвратного тифа (спирохет и риккетсий) Заражение – контаминация – происходит при раздавливании вши и втирании гемолимфы в ранки на коже
Источники и способы проникновения паразитов в организм человека 5) гемотрансфузионный (при переливании крови и пересадке органов) –токсоплазма, малярийный плазмодий 6) трансплацентарный (через плаценту) – токсоплазма 7) воздушно-капельный - пневмациста 8) трансовариальный – возбудитель передается от хозяина следующему поколению через стадию яйца
Способ заражения Источник заражения ПИЩА, ВОДА, КРОВЬ ПЕРОРАЛЬНЫЙ, ПРИ ПЕРЕЛИВАНИИ КРОВИ, ВРОЖДЕННЫЙ
Toxoplasma gondi Человек – только промежуточный хозяин Инфекционные стадии: - ооциста (пероральный способ заражения) - трофозоит (при переливании крови и трансплацентарно)
Toxoplasma gondii Тканевые цисты в ткани головного мозга
Церебральный абсцесс, вызванный токсоплазмой
При врожденном токсоплазмозе инфекция передается от матери ребенку через плаценту (трансплацентарно)
Проявлениями у ребенка могут быть: слепота, глухота, эпилепсия или психические расстройства
Девочка с гидроцефалией при врожденном токсоплазмозе
ГЕОГРАФИЧЕСКОЕ РАСПРОСТРАНЕНИЕ ПАРАЗИТОВ Географическое распространение паразитов связано с распространением их хозяев и с особенностями физико-географической среды данного района. В пределах своего ареала паразиты распространены не повсеместно, а лишь в определённых местообитаниях. На распространение паразитов существенное влияние оказывает образ жизни хозяев (способ питания, миграции, спячка), размеры ареала, особенности ландшафтно-климатического фактора, доместикация и другие факторы.
АДАПТАЦИИ ПАРАЗИТОВ 1. Мощное развитие половой системы
АДАПТАЦИИ ПАРАЗИТОВ 2. Паразиты имеют огромную фертильность (плодовитость)
Самка Trichocefalus trichiurus (власоглава) откладывает около 5 000 яиц в день
Одна оплодотворенная самка Anculostoma duodenale откладывает около 25 000 to 30 000 яиц в день

